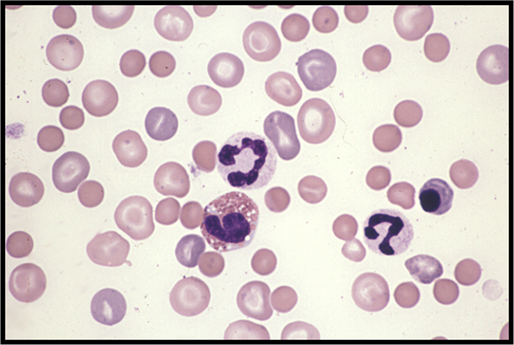

Academy of Veterinary
Academy of Veterinary
Clinical Pathology Technicians
Promoting Excellence in Veterinary Clinical Pathology
AVCPT
United States
info
FAQ
FAQ
- Why did we form the Academy of Veterinary Clinical Pathology Technicians (AVCPT)?
We established the AVCPT to promote an expansion of knowledge and education of veterinary clinical pathology among credentialed veterinary technicians. This will help the welfare of the patient through the high standards of practice for those who become credentialed in clinical pathology, and will benefit the veterinarian, veterinary technician and the animal guardian by establishing education and experience prerequisites. AVCPT will also strive to facilitate the education of the veterinary community by encouraging attendance at continuing education meetings, participation in webinars, research, oral presentations, and journal articles.
- What are the benefits of certification in AVCPT for a veterinary technician?
A VTS in clinical pathology will be able to demonstrate that she/he is capable of achieving superior knowledge in the discipline and has a high level of ability in the performance of laboratory techniques in comparison to the general veterinary technician. Recognition by AVCPT provides a way to enhance your personal growth and career, as well as promote excellence in the field of clinical pathology. One cannot predict if it will lead to an increase in salary, but it will demonstrate your commitment to excellence both personally and professionally.
- What requirements do I need to meet to be able to apply for AVCPT certification?
- Current candidate requirements state:
- One must be a graduate of an AVMA accredited Veterinary Technology program and/or credentialed to practice as a Veterinary Technician in a State or Province of the United States, Canada, or other country.
- In states that do not offer credentialing, applicants must show evidence of a passing score on the Veterinary Technician National Exam (VTNE). Applicants from another country shall be credentialed by their country of residence.
- The candidate must be a member of NAVTA, capable of showing proof of current membership.
- What would I have to complete before I could become eligible to take the certifying examination for AVCPT?
After graduating from an accredited Veterinary Technology program and/or becoming credentialed to practice as a Veterinary Technician (or its equivalent), candidates must meet education and experience requirements, as specified:
- A minimum of three years and 4,000 hours of work experience in the field of veterinary clinical pathology.
- A minimum of forty continuing education (CE) clock hours related to veterinary clinical pathology. The continuing education must be received from an accredited veterinary technician school, school of veterinary medicine, RACE Approved CEs, national/state/local conferences with approved CEs. Proof of attendance is required. No more than 25% may come from electronic or printed sources.
- All experience and continuing education must be completed within six years prior to the application.
Provide the documentary evidence of advanced competence in veterinary clinical pathology.
- Completion of the veterinary clinical pathology skills form. The skills form will document skills that have been mastered by the candidate and are necessary to practice as a veterinary technician at an advanced level within the field of clinical pathology. This form will be provided by the credentials approval committee. It is subject to change based upon the current state of the art in veterinary clinical pathology.
- A case log is maintained for the length of time necessary to complete all the required skills, within the three years immediately preceding the submission of the application.
- Three detailed case reports. Case reports must demonstrate expertise in the collection, handling, and processing of patient samples requiring laboratory/pathology services. The case report must also demonstrate knowledge and understanding of disease processes and pathology of the patient. The case reports should be selected from the case log. Case reports must be the original work of the applicant.
- Two letters of recommendations from two different categories: an AVCPT member, a supporting veterinarian, supporting credentialed technician, a member of the American Society of Veterinary Clinical Pathology (ASVCP), or a veterinary technology specialist (VTS) in any of the NAVTA approved specialties.
- Standard operating procedures (SOPs), quality assurance (QA) and quality control (QC) procedures.
- Skills, case logs, case reports, letters of recommendation, and SOPs must be completed within the three years immediately prior to submission of the application.
- Can I count work experience I gained before becoming a credentialed veterinary technician?
No, specialties exist to provide credentialed veterinary technicians a way to focus in a particular discipline. What you have learned from previous experience may benefit you indirectly but only experience gained after your graduation from an AVMA accredited Veterinary Technology program or on the date of legal recognition to practice as a veterinary technician in some state or province of the United States, Canada or other country can be applied towards your certification process through AVCPT.
- What if I currently work at a facility that does not have certain instrumentation or we do not perform some of the tests listed on the skills list?
The skills form includes both core skills and supplemental skills. AVCPT candidates must demonstrate mastery of 100% of the listed core skills and 25 individual skills of the candidate’s choice from the supplemental skills list. AVCPT has taken facility variances into account by allowing the candidate to choose from an extensive list of supplemental skills to complete 25 of his/her choice. If needed, candidates may have to seek additional experience at another facility. In the future AVCPT hopes to provide a list of facilities that may be able to offer additional assistance.
- If I work in a small animal, specialty, or exotic practice; will I still be able to complete the application requirements?
You should be able to complete the application requirements in most settings. If you notice on the species requirement under the case logs, you could submit 90% of cases from one species as long as 10% came from at least one additional species. In regard to the skills list, any skills that you cannot obtain in your practice may be mastered at another facility.
- I went to the link and saw the requirements but how do I get the forms that are mentioned. I didn't see any place to down load them?
If you visit the candidate packet link, there are sub-pages listed for the components of the packet. The skills list is located at the bottom of the skills page. If you visit the case log page, click on the CBC Case log form that is underlined. The candidate information form links are under the candidate information page. The forms are in pdf format. You may have to download a free pdf reader in order to view them and enter the information. A link to the free reader may be found at the bottom of the page. These forms can be saved to your computer and edited.
- What is the cost involved for the exam?
The cost varies depending on the location and costs associated with administering the exam. The fees are split into two payments; an application fee and examination fee.
- What information do you need up front (i.e.: recommendation letter, essay, etc.) and when is everything due?
All candidate application packet materials (Parts I and II) are due by January 15th.
- I don’t think I will be able to finish the candidate application by the deadline. What do I do?
If you are unable to complete the packet by the deadline for the exam, continue logging cases, skills, and reports until the next exam deadline. The candidate packet is updated as needed. Candidates will be responsible for submitting the packet that meets current requirements.
- Should all forms be hand written and sent in as is or do you want them typed?
The forms listed are fill-able and save-able in the pdf format. All documents must be typed before submission.
- Can I include additional cases or letters of recommendations in case some are thrown out during the approval process?
Only two letters of recommendation should be submitted. Case reports are very comprehensive so we require only one of each of the three areas (hematology, chemistry, and urinalysis). Only one of each type of case report should be submitted. If an application is not approved, the candidate may appeal. Appeals are evaluated on an individual basis and the candidate may be asked to provide additional material as requested.
- Do I have to work with the person who writes my letter of recommendation?
You don't have to have work with the person to get them to write a letter of recommendation. You could utilize a colleague from another clinic who is a credentialed technician, VTS in one of the other specialties, or a pathologist. You can also utilize contacts that you make at seminars or the pathologist that you submit samples to at a diagnostic facility. The letter just has to attest to your character, integrity, professional ethics, and technical ability and should be someone who can provide an honest assessment.
- I started the application packet and the veterinarian who was signing off on my skills has since left our practice. Do I have to start over with another veterinarian?
No, you do not have to start all over. You can have additional persons signing off on your skills as long as we have current contact information for each one.
- For the skills list can we have as many doctors and VTS technicians as needed to sign off on our skills or do you want only a specific amount?
The skills can be signed by the most qualified person to verify that particular skill. There can be more than one person. There are up to five places for signatures and additional sheets can be added. AVCPT requires that a licensed veterinarian or veterinary technician specialist (VTS) attest to your ability to perform the task. Each skill should be verified and signed by the licensed veterinarian or veterinary technician specialist who is most qualified to verify the skill.
- I work in a very specialized lab and run several tests that are not listed on the skills form. What is the process of having supplemental skills approved?
- Candidates can add ten supplemental skills. You can submit the request by e-mail by listing the test name and one or two sentences on methodology for tests that need approval. You will need to keep a copy of the approval e-mail and send it in with your application packet as confirmation that the tests have been approved.
- What do I do with the knowledge list, there are no instructions?
This list is to help you in preparing for the examination and includes items that a potential candidate should know.
- I was under the impression that there would be classes offered to become certified. Is this not true?
No, Veterinary Technician Specialties are designed to promote experienced technicians in the field by recognizing them as experts in their chosen area of concentration. Additional education requirements come from outside sources. You can visit https://www.navta.net/specialties/specialties for more information on specialties.
Additional FAQ's relating to case logs and reports can be found here.
Didn't see your question here? Contact us
Canine peripheral blood film, Wright’s stain, 100x.
Photo courtesy of Pam Schendel
Copyright 2017 AVCPT. All rights reserved.
AVCPT
United States
info